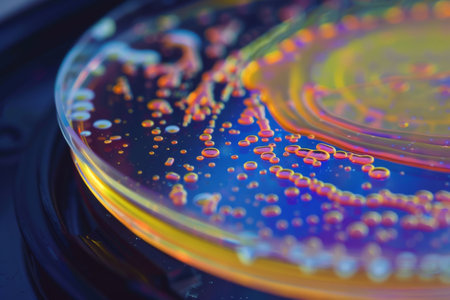
The mesmerizing movements of bacteria on a petri dish --ar 3:2 Job ID: 2c77d82d-b08e-4819-8834-bce1cc30607fの素材

素材 - The mesmerizing movements of bacteria on a petri dish --ar 3:2 Job ID: 2c77d82d-b08e-4819-8834-bce1cc30607f
作品情報
The mesmerizing movements of bacteria on a petri dish --ar 3:2 Job ID: 2c77d82d-b08e-4819-8834-bce1cc30607f
- ID:271973263
- 作品種別:
- 作者名:Tanmoy Chandro Das
キーワード
- analyzing
- argentina
- biology
- biotechnology
- blood
- chemical
- chemistry
- choice
- close-up
- color image
- concepts
- confidence
- coronavirus
- creativity
- cultivated
- defocused
- development
- discovery
- dna
- efficiency
- engineering
- examining
- expertise
- futuristic
- horizontal
- illness
- illuminated
- innovation
- laboratory
- males
- medicine
- microbiology
- microscope
- mid adult
- occupation
- one person
- people
- perfume
- pharmacy
- research
- science
- scientist
- teamwork
- technician
- technology
- uk
- vaccination
- vial
- virus
類似作品
close-up of vib...
A close-up of a...
Close-up of a c...
A vibrant displ...
This macro show...
Close up petri ...
Close up petri ...
Backgrounds of ...
This macro show...
close-up of col...
In the microsco...
Explore the uns...
Colorful variet...
A petri dish te...
Abstract Petri ...
This vivid view...
A petri dish te...
The mesmerizing...
The mesmerizing...
A petri dish wi...
Various types o...
Generative AI :...
Top view of a p...
Close up of bac...
A close-up of p...
Backgrounds of ...
bacterial colon...
Petri dish with...
Glowing colonie...
microbial cultu...
In the microsco...
Petri dishes co...
Abstract labora...
Petri plate wit...
Backgrounds of ...
colorful cymati...
Shimmer bubbles...
The mesmerizing...
Various types o...
colorful bacter...
microbial cultu...
A petri dish wi...
The mesmerizing...
Bacteria in a p...
Metallic drop o...
The mesmerizing...
microbial cultu...
Various types o...
Close up petri ...